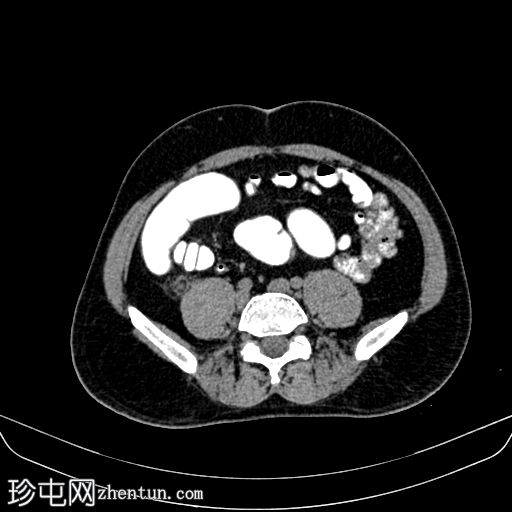
1.jpg
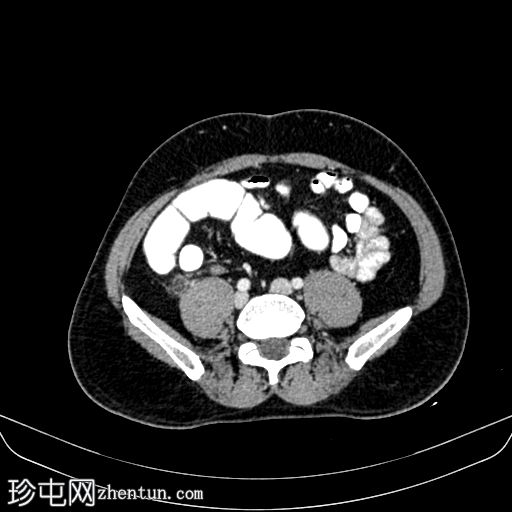
3.jpg

临床表现
右下腹疼痛。
患者资料
年龄:55岁
性别:男
CT
轴位
平扫
轴位增强扫描
动脉期

轴位增强扫描
门静脉期
矢状位增强扫描
门静脉期

冠状位增强扫描
门静脉期

平扫CT显示,盲肠后外侧壁旁可见一边界清晰的卵圆形脂肪密度影,周围环绕一薄层高密度环(“高密度环”)。周围脂肪间隙轻度改变,无游离液体,邻近结肠壁未见增厚。动脉期,病灶仍为脂肪密度影,高密度环略有强化;未见动脉出血。
门静脉期,可见一持续存在的脂肪密度影,周围环绕高密度环;周围脂肪条索状改变,无脓肿形成,邻近结肠无憩室,盲肠壁正常。无阑尾炎,无淋巴结肿大,无游离气体或液体。
病例讨论
关键教学要点:
识别邻近结肠的高密度环状脂肪衰减病变
检查是否存在明显的结肠壁增厚、憩室或阑尾肿大
了解大网膜阑尾的解剖分布及其常见位置
认识到正确诊断可避免不必要的手术 |